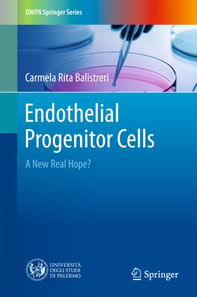
Endothelial Progenitor Cells

Endothelial Progenitor Cells
This book explores the role of endothelial progenitor cells (EPCs) in the context of regenerative medicine (RegMed). In particular, it reveals the value of RegMed as a new TM branch intended to improve the health and quality of life, by restoring, maintaining or enhancing tissue and functions of organs.
The book is divided into three chapters, the first of which describes the relevance of translat...
This book explores the role of endothelial progenitor cells (EPCs) in the context of regenerative medicine (RegMed). In particular, it reveals the value of RegMed as a new TM branch intended to improve the health and quality of life, by restoring, maintaining or enhancing tissue and functions of organs.
The book is divided into three chapters, the first of which describes the relevance of translat...
